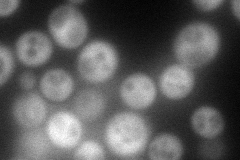
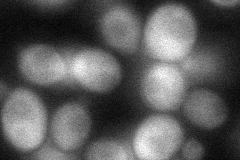
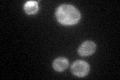

View description
Protein with a role in maintenance of cellular integrity, interacts with components of the TOR pathway; ssd1 mutant of a clinical S. cerevisiae strain displays elevated virulence
Localization:
Intensity:
Fold change:
Significance:
-
C’ GFP library in SD

cytosol70.02 -
N' NOP1pr-GFP in SD
cytosol117.066 -
N' TEF2pr-mCherry in SD

cytosol123.644 -
N' NATIVEpr-GFP in SD

cytosol56.5744 -
N' TEF2pr-VC and Cyto-VN in SD
cytosol57.507 -
C’ GFP library in SD+DTT

cytosol110.521.57Yes -
C’ GFP library in SD+H2O2

cytosol75.841.08No -
C’ GFP library in Starvation Media
cytosol83.021.18No -
C’ GFP library on the background of Pup2-DaMP

cytosol -
C’ GFP library on the background of CCT mutant

cytosol78.39171.11942No
